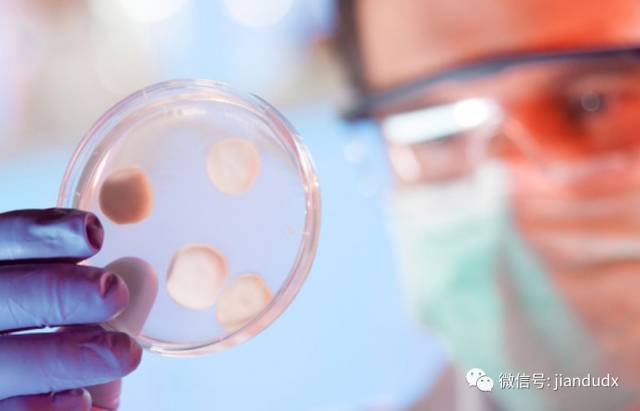

通过最前沿的“离子通道功能检查系统”精确锁定大脑神经细胞膜上的微小孔膜——神经离子通道异常病变,精细捕捉癫痫病灶。在此基础上进行在最短时间内,迅速控制发作,消除头晕、头痛、恶心、呕吐等临床症状,最大程度减轻癫痫患者的痛苦。
打破“抗药性” 逐渐减药、停药
恢复正常脑电信号传导
超微导入技术将修复离子通道的特异性生物蛋白靶向性导入病灶,无创修复病变离子通道,使其恢复正常“开”、“关”功能,使带电离子正常流动,恢复正常脑电信号传导,打破因长期服药导致的“抗药性”,为逐渐减药、停药打好治疗基础。
修复脑损伤
逐渐恢复智力、反应能力
采用神经谐振激活疗法,快速激活大脑中负责清除神经毒性物质、合成神经营养因子的星形胶质细胞,促进神经元生长,延长神经元寿命“治疗 + 修复”双管齐下,疗效更稳定。让病人在摆脱药物依赖的情况下,也能逐渐修复脑损伤,恢复受损智力、认知、反应能力,改善记忆力减退、多动、学习困难、精神障碍等脑神经组织后遗症,让患者真正回归健康生活。
国家疾病防控中心临床调查:
3928位癫痫患者接受离子通道修复治疗后的反应
国家癫痫病防控中心在对 3928 位癫痫患者接受治疗、出院后 24 个月的临床观察、康复回访显示,通常接受神经离子通道修复治疗后,患者在这四个阶段会有以下感觉和改变。
接受治疗中
89.1% 的癫痫病人接受治疗时表示,修复离子通道病变的过程基本没有疼痛感,略有头皮发麻的感觉,相当于轻微针刺的触感,治疗不需要开颅手术,头上不会留疤或存在创伤。
接受治疗后
92% 的癫痫病人表示,在接受离子通道修复治疗后,1-3 天内发作得到有效控制,发作频率明显减少,3-7 天后发作基本得到控制,癫痫持续状态消失,身体燥热、口干口苦、四肢酸痛等不适感消失,7-15 天后,因长期吃药导致的头晕、头痛、恶心、呕吐、食欲不振等症状逐渐消失,睡眠质量有所提高。
康复出院后
失神、愣神、发呆时间逐渐减少,精神不振、嗜睡等症状逐渐消失。面色逐渐红润,睡眠质量逐渐好转。头脑感觉不再昏沉,逻辑比以前清楚。之前偶尔会出现幻觉、错觉、眩晕感的病人自述,这些症状通常在 1-3 个月内逐渐消失。反应不灵敏的病人,反应能力逐渐增强。
减药停药后
86.9% 病人及家属反映,减药、停药未出现癫痫发作,经常短暂失神,头痛、之前有发怒打人等暴力倾向者,脾气暴躁、情绪焦虑等消失,曾有肢体麻木、刺痛或感觉全身无力的病人,麻木、刺痛感消失,精神状态良好,因为减少用药,药物对胃肠、肝脏所产生的不适反应降低、消失。超过 85% 的病人表示,在医生指导下停药后,自己的智力、记忆力慢慢增强,复查大脑电信号传导正常。
- 上一篇:北京癫痫医院 癫痫频繁发作... 下一篇:很抱歉没有了
相关文章推荐
北京建都癫痫医院
医保定点医院
地址:北京市丰台区南三环赵公口桥南光彩路
康复咨询热线:010-59129966
本站信息仅做健康参考,具体诊疗请遵医师意见



